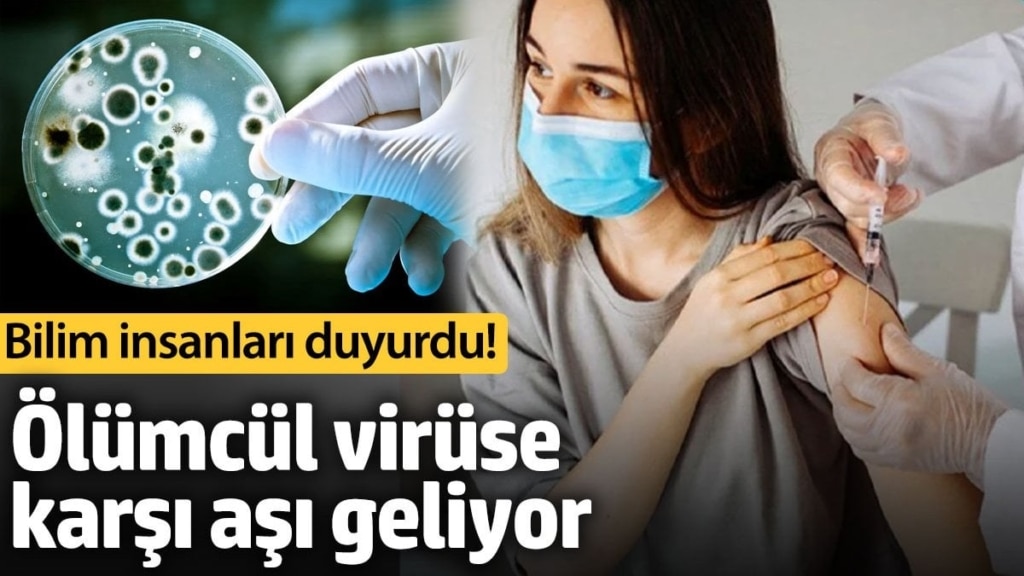
featured

Hepatit C virüsü, dünya genelinde milyonlarca insanı etkileyen ve ciddi sağlık sorunlarına yol açan bir patojendir.
Bilim insanları, son araştırmalarında Hepatit C virüsünün hücreleri nasıl enfekte ettiğini açıkladı. Bu önemli buluş, virüse karşı aşı geliştirilmesi için yeni bir umut sundu.
Bu virüs, dünya genelindeki 58 milyon insanın kronik iltihap yaşamasına neden oluyor ve her yıl 300 binin üzerinde ölüme sebep oluyor. Mevcut tedavi yöntemleri, virüsün yayılmasını yeterince durduramıyor ve bu nedenle aşı geliştirme çalışmaları sürdürülüyor. Ancak, virüsün hücrelere nasıl girdiğinin anlaşılmaması önemli bir engel oluşturuyordu.
Kopenhag Üniversitesi’nde yürütülen disiplinler arası araştırma ekibi, bu sorunun çözümünde son derece önemli bir aşama kaydetti.
“VİRÜSÜN HÜCREYE GİRİŞİ İÇİN ÖNEMLİ BİR KEŞİF”
Kopenhag Üniversitesi’nden Doçent Dr. Jannick Prentø, “Hepatit C virüsünün hücrelere bağlanmasını sağlayan ilk protein kompleksini keşfettik. Bu buluş, virüsün hücrelere giriş mekanizmasını anlamamızda önemli bir adım” şeklinde açıklamada bulundu.
Yeni elde edilen bilgiler, virüsün hücrelere girişini engelleyebilecek bir aşı geliştirilmesine olanak tanıyabilir. Post-doktora araştırmacısı Elias Augestad da, “Bu protein kompleksinin yapısını çözmemiz, virüsün hücrelere enfekte olmasını önleyecek aşı adayları tasarlamamıza imkan tanıyacak” ifadelerini ekledi.
Hepatit C virüsündeki hücreye bağlanmayı sağlayan protein kompleksinin yapısının, koronavirüsteki “diken proteini”ne benzediği belirtildi.
Ancak, Hepatit C’deki bu proteinlerin işlevleri farklılık gösteriyor. Virüsün hücreye giriş mekanizması ise benzer prensiplerle çalışmakta. Bu çalışma, aşı geliştirilmesi için önemli bir temel oluşturdu.
Bilim insanları, bu yeni buluş sayesinde bağışıklık sisteminin Hepatit C virüsünün yüzeyine bağlanacak antikorlar üretmesini ve böylece virüsü etkisiz hale getirmeyi amaçlıyor.
“LABORATUVARDA GÜÇLÜ BİR ZORLUKLA KARŞILAŞTIK”
Doç. Dr. Jannick Prentø, “Bu protein komplekslerini laboratuvar ortamında üretmek ve incelemek son derece zordu. Ancak bu zorlukları aşarak, virüsün yüzeyindeki protein yapısını anlamayı başardık” şeklinde belirtti.
Araştırma ekibi, virüsün bu hassas yapısını keşfetmenin, aşı geliştirme süreçlerini hızlandıracağını ifade etti. Kopenhag Üniversitesi Sağlık ve Tıp Bilimleri Fakültesi’nin iki bölümü tarafından gerçekleştirilen bu çalışma, Nature dergisinde yayımlandı.
Araştırmayı yürüten Doç. Dr. Jannick Prentø ve Post-doktora araştırmacısı Elias Augestad, virüsün hücrelere giriş mekanizmasını anlamak için yapısal protein uzmanları ile işbirliği içerisinde çalıştı. Bu süreçte, Doç. Dr. Pontus Gourdon ve meslektaşı Kaituo Wang, virüsün yüzeyindeki proteinlerin yapısının çözülmesinde kritik bir rol üstlendi.